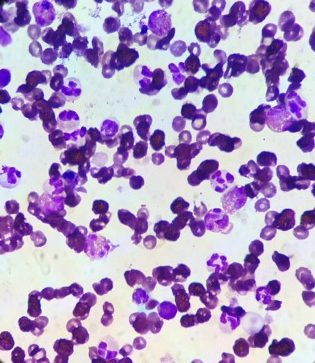

La furonculose eosinophilique est une dermatose d’apparition aigue caractérisée par des lésions généralement douloureuses, ulcéro-crouteuses, localisées au niveau du chanfrein. Des morsures d’arthropodes ou d’insectes sont fortement suspectée comme cause sous-jacente.
Caroline Léonard
Catherine Laffort
Clinique Vétérinaire Alliance, Bordeaux
Décembre 2019
Historique
Une chienne femelle stérilisée Setter anglais de 6 ans est présentée en consultation de dermatologie pour l’évaluation de lésions croûteuses et suppurées, localisées au niveau du chanfrein et des babines d’apparition aigue. Un prurit intense est rapporté avec frottements de la face mais la chienne n’est pas abattue. Un gonflement du chanfrein a tout d’abord été observé avant une l’évolution rapide vers les signes cliniques observés le jour de la consultation. Une injection de corticoïdes à dose anti-inflammatoire et une antibiothérapie bien conduite (amoxyclav) ont permis une légère amélioration transitoire. La chienne présente souvent un comportement de fouissage dans les feuillages.
Examen clinique
L’examen clinique montre une chienne en bon état général.
L’examen dermatologique met en évidence des lésions ulcéro-croûteuses localisées au niveau du chanfrein, épargnant la truffe, et des babines. Des nodules, souvent ulcérés, sont observés en périphérie, surtout à hauteur des babines. (figure 1 et 2)
Figure 1 et 2 : images de lésions ulcératives et croûteuses localisées au niveau du chanfrein. Des nodules ulcérés et crouteux sont également observés au niveau des babines.
Hypothèses diagnostiques
Furonculose eosinophilique
Pyodermite nasale
Dermatophytose
Démodécie
Dermatose auto-immune, par exemple pemphigus foliacé, pemphigus érythémateux
Examens complémentaires
Les raclages cutanées réalisés niveau des lésions ne révèlent aucun élément parasitaire ou fongique. La culture mycologique est négative.
Un calque cutané par impression au niveau des lésions montre la présence de nombreux polynucléaires éosinophiles. Des polynucléaires neutrophiles associés à des images de phagocytose de cocci sont aussi observés. (figure 3)
Figure 3 : image d’un calque par impression des lésions mettant en évidence de nombreux éosinophiles (flèche). Des polynucléaires neutrophiles sont aussi observés (tête de flèche).
La culture bactérienne réalisée à partir d’un échantillon sous-crustacé a permis d’isoler Staphylococcus pseudintermedius. Cette bactérie est donnée comme sensible aux betalactamines sauf la pénicilline G, la Gentamicine, les Fluoroquinolones, la Tetracycline et l’association Triméthoprime/Sulfamides. Une résistance à la Penicilline G, la Streptomycine, la Lincomycine, le Chloramphénicol et l’Acide fusidique est notée.
L’examen histopatholgique de biopsies cutanées est compatible avec des lésions évoluées ou remaniées de furonculose éosinophilique.